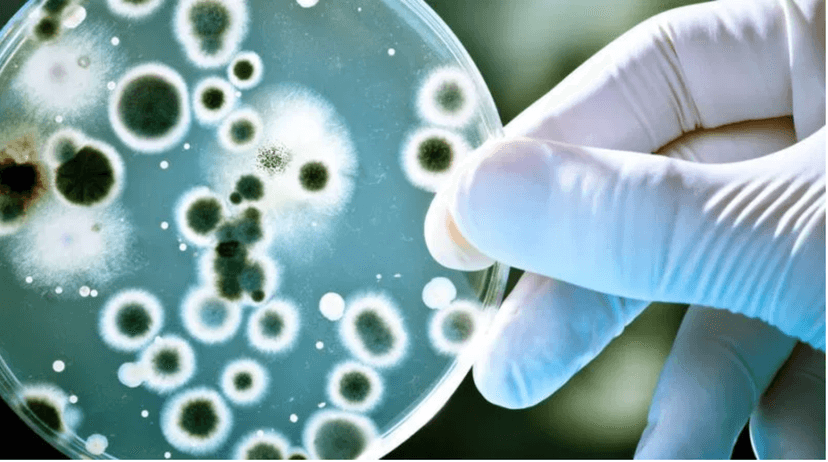
Imagen de portada de Microbiología: el estudio de lo invisible al ojo humano

¿Qué hace el profesional en microbiología?
Estudian la composición tanto química como la biología de los microbios causantes de enfermedades, como la gripe, malaria e inclusive intoxicaciones alimentarias, entre otras.
Luego, estos aplican sus conocimientos en las diferentes áreas como: producción de alimentos, agricultura, la industria del agua, medicina y productos farmacéuticos, encargándose de gestionar y proteger el medio ambiente.
¿Cuál son algunos de sus campos de trabajo?
Estos dependerán del área en que se desempeñen, por ejemplo: cuando laboran en un hospital, pasan de microbiólogos a biomédicos y científicos clínicos, para averiguar cuáles microbios son los responsables de las enfermedades que presentan los pacientes.
Por su parte, pueden también utilizar sus hallazgos fuera del laboratorio para resolver diversos problemas en la agricultura, o incluso como ayudantes en ingenierías para la recolección de residuos.Los microbiólogos estudian un microorganismo en particular, desde sus características, hasta su estructura celular y genética.
Habilidades deseadas de esta profesión:
- Interés por las ciencias
- Gusto por la investigación
- Capacidad para trabajar en equipo
- Facilidad para actualizar conocimientos en ciencias y química
- Valores culturales, éticos y profesionales
- Habilidades de comunicación y expresión
Perfil profesional
- Poner atención al detalle
- Habilidades de trabajo en equipo
- Capacidad para resolución de problemas
- La capacidad de organización para experimentos
Competencias
- Aptitudes matemáticas
- Innovador
- Metódico
- Observador
- Sensato
- Preciso
Recuerda que en universidades.pa puedes encontrar mucha más información, acerca de carreras y las distintas universidades del país, así como alguno consejos, para que puedas ampliar tus conocimientos y seas mejor en lo que haces.